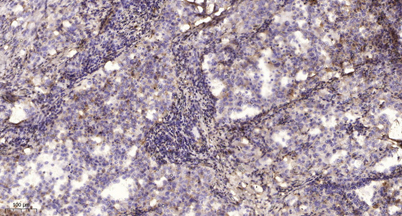

Overview
-
 Western Blot analysis of various cells using Na+ CP type IIβ Polyclonal Antibody
Western Blot analysis of various cells using Na+ CP type IIβ Polyclonal Antibody -
 Western blot analysis of SCN2B Antibody. The lane on the right is blocked with the SCN2B peptide.
Western blot analysis of SCN2B Antibody. The lane on the right is blocked with the SCN2B peptide. -
 Western blot analysis of the lysates from HepG2 cells using SCN2B antibody.
Western blot analysis of the lysates from HepG2 cells using SCN2B antibody. -
Immunohistochemical analysis of paraffin-embedded human lung cancer. 1, Antibody was diluted at 1:200(4° overnight). 2, Tris-EDTA,pH9.0 was used for antigen retrieval. 3,Secondary antibody was diluted at 1:200(room temperature, 45min).
Immunohistochemical analysis of paraffin-embedded human lung cancer. 1, Antibody was diluted at 1:200(4° overnight). 2, Tris-EDTA,pH9.0 was used for antigen retrieval. 3,Secondary antibody was diluted at 1:200(room temperature, 45min).
關閉
在線咨詢
Online consultation
-
在線咨詢
-
技術支持

關注微信公眾號



 下載說明 ①
下載說明 ①



